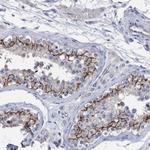
PPP3CC Antibody in Immunohistochemistry (Paraffin) (IHC (P))

Search
Invitrogen
PPP3CC Polyclonal Antibody
{{$productOrderCtrl.translations['antibody.pdp.commerceCard.promotion.promotions']}}
{{$productOrderCtrl.translations['antibody.pdp.commerceCard.promotion.viewpromo']}}
{{$productOrderCtrl.translations['antibody.pdp.commerceCard.promotion.promocode']}}: {{promo.promoCode}} {{promo.promoTitle}} {{promo.promoDescription}}. {{$productOrderCtrl.translations['antibody.pdp.commerceCard.promotion.learnmore']}}
产品信息
PA5-82830
种属反应
宿主/亚型
分类
类型
抗原
偶联物
形式
浓度
规格
纯化类型
保存液
内含物
保存条件
运输条件
RRID
产品详细信息
Immunogen sequence: RGFSLQHKIR SFEEARGLDR INERMPPRKD SIHAGGPMKS VTSAHSHAAH RSDQGKKAHS
Highest antigen sequence indentity to the following orthologs: Rat - 58%, Mouse - 59%.
靶标信息
Calmodulin-dependent protein phosphatase, calcineurin, is involved in a wide range of biologic activities, acting as a Ca(2+)-dependent modifier of phosphorylation status. In testis, the motility of the sperm is thought to be controlled by cAMP-dependent phosphorylation and a unique form of calcineurin appears to be associated with the flagellum. The calcineurin holoenzyme is composed of catalytic and regulatory subunits of 60 and 18 kD, respectively. At least 3 genes, calcineurin A-alpha, calcineurin A-beta, and calcineurin A-gamma (CALNA3), have been cloned for the catalytic subunit. These genes have been identified in humans, mice, and rats, and are highly conserved between species (90 to 95% amino acid identity).
仅用于科研。不用于诊断过程。未经明确授权不得转售。
篇参考文献 (0)
生物信息学
蛋白别名: Calcineurin A gamma; Calcineurin, testis-specific catalytic subunit; Calmodulin-dependent calcineurin A subunit gamma isoform; CAM-PRP catalytic subunit; protein phosphatase 3, catalytic subunit, gamma isozyme; Serine/threonine-protein phosphatase 2B catalytic subunit gamma isoform; unnamed protein product
基因别名: CALNA3; CNA3; PP2Bgamma; PPP3CC
UniProt ID: (Human) P48454
Entrez Gene ID: (Human) 5533